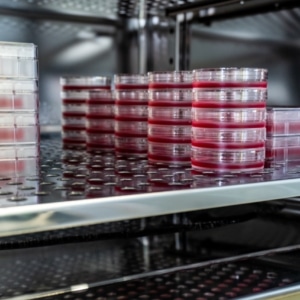

Die ganzheitliche Basis für modular erweiterbare Steuerung und Kontrolle komplexer Peltier-Systeme
Mit dem PELCORE TEC-Controller und dazugehörigem Zubehör schafft die Dr. Neumann Peltier-Technik (DNPT) die erste ganzheitliche Basis zur vollumfänglichen Steuerung und Überwachung thermoelektrischer Gesamtsysteme. Die PELCORE TEC-Controller stehen für höchste Präzision in der Temperaturregelung und bieten eine Stabilität von ±0,01 °K selbst in herausfordernden Anwendungen. Dank USB-, UART- und I²C-Schnittstellen lassen sich die Controller in bestehende Systeme integrieren, während Überstrom- und Überhitzungsschutz sowie minimale Restwelligkeit maximale Sicherheit gewährleisten.
Das Portfolio der PELCORE TEC-Controller umfasst PWR-CTRL TEC-Controller – das Herzstück präziser und zuverlässiger Peltier-Temperierung – sowie Plug-and-Play-integrierbare Erweiterungs-PCBs. Hierzu zählen COMM-Boards zur flexiblen Anbindung von Kommunikationsschnittstellen und Webserver-Erweiterungen, Converter-Boards zur Integration von Spannungs- und Steuersignalen für Peripheriekomponenten sowie Erweiterungen zur nahtlosen Einbindung verschiedener Displayoptionen.
Mit Ausgangsleistungen von 150 W bis 1.500 W, kompakter Bauweise und modularer Erweiterbarkeit eignen sich die DNPT TEC-Controller ideal für industrielle, medizinische und wissenschaftliche Anwendungen, die eine präzise Temperaturregelung erfordern. Sie unterstützen sowohl statische als auch dynamische Regelaufgaben und ermöglichen die nahtlose Integration von Sensorik, Lüftern, Pumpen sowie weiteren Peripheriegeräten. Für maßgeschneiderte Lösungen und individuelle Anforderungen bieten die TEC-Controller eine zuverlässige und präzise Temperaturkontrolle – und tragen gleichzeitig zu einer verlängerten Lebensdauer der Peltier-Elemente bei.